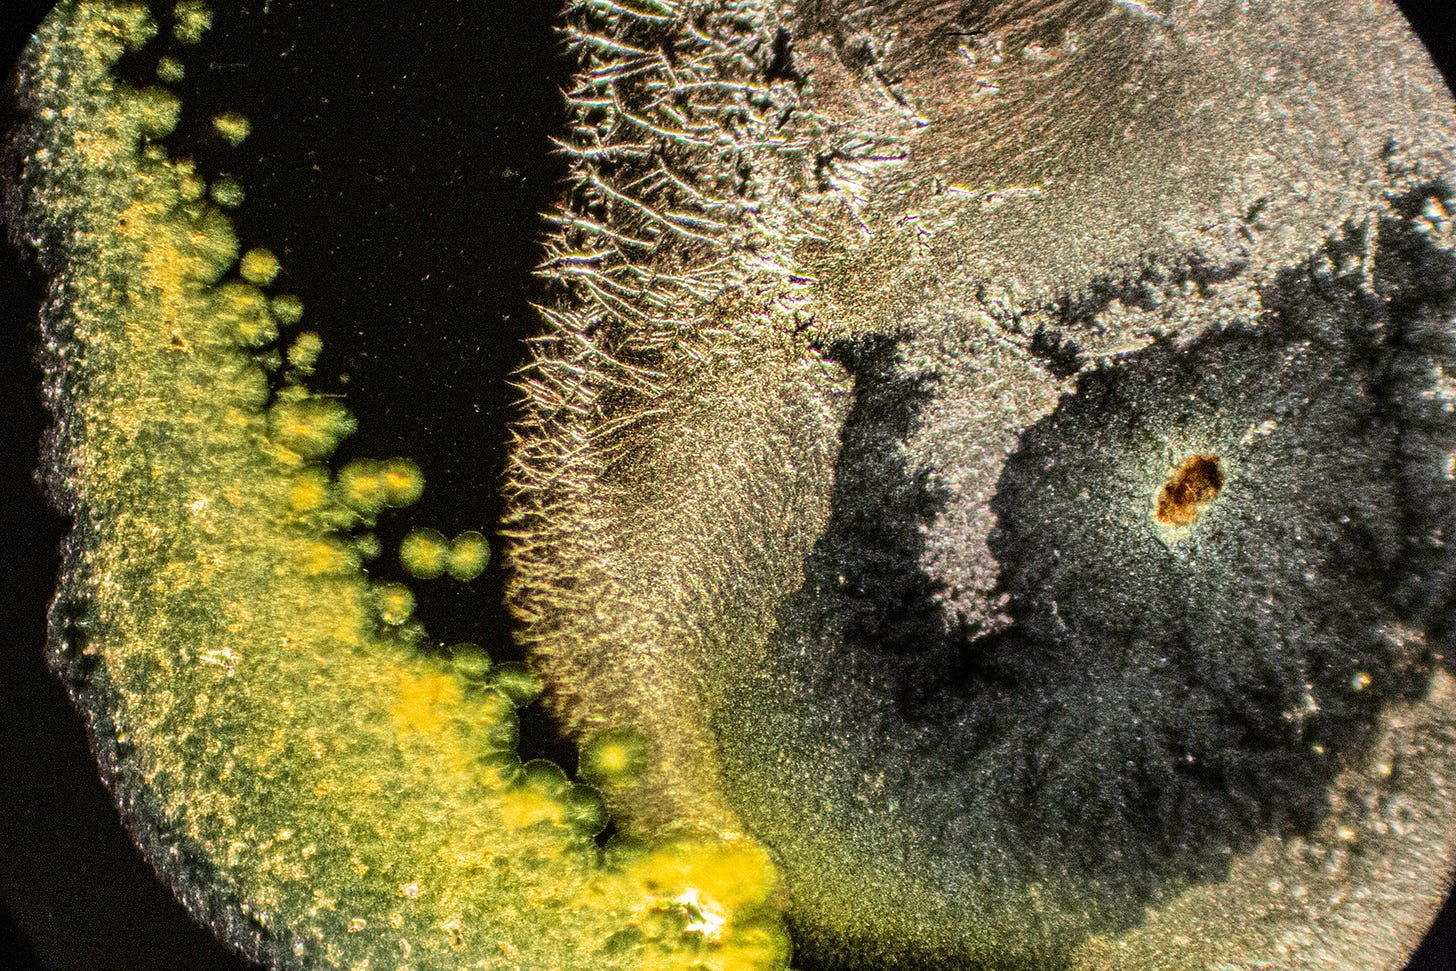

Methotrexate Chemo Injection
Microscopy Investigations into Pharmaceuticals
Methotrexate (MTX) is a immunosuppressant chemotherapy drug, previously known as amethopterin. Methotrexate interferes with the growth of certain cells of the body, especially cells that reproduce quickly, such as cancer cells, bone marrow cells, and skin cells. (But doesn’t harm other cells, kind of like Herbicides"??) Its also prescribed for Rheumatoid Arthritis.
This sample was an intramuscular injectable. Trade names include Trexall, Rheumatrex, and Otrexup.
A simple search from good ol’ Wikipedia tells us this:
Read More Side Effects (including Death) here! -https://www.drugs.com/sfx/methotrexate-side-effects.html
and here’s 48 pages by the good ol’ FDA - https://www.accessdata.fda.gov/drugsatfda_docs/label/2011/011719s117lbl.pdf
Hmmm…..Wonder what does it mean when a cancer-curing drug inhibits the function of a cancer-producing nanotech bioweapon?
At first look, without a coverslip, I attempted to do the same kind of Sessile Droplet Evaporation process we do with Dental Anesthetics to see if the particles would assemble a formation of technology, a liquid crystal. This was a much thinner liquid than Dental Anesthetic injections.
All images are in Darkfield.
This is what happened: Yes, a separation of particles and ingredients, but no formation of a complex geometric crystal using sodium as a scaffold.
There was definitely Hydrogel Polymer formations, however.
After One Week under the cover-slip, the Methotrexate formed these very interesting irregular feather-fan-flower-burst crystals, that I have not seen anywhere else. I do not think that this is indication of Nanotech, but of the chemical itself. They are pretty, but in a disturbing, artificial way, like some, well, pharmaceutical-based nightmare. You would think if it was healing these formations would be more harmonic. Reminds me of that Masaru Emoto water thing where you say nasty things to it and it makes ugly snowflake looking crystals. “I hate you cells!”
Now we see familiar Hydrogel Polymer-forming “Smart Cities” - my term for complex straight-lined and geometric shaped crystal formations that resemble birds’ eye architectural blueprints, runways or, circuit boards. Sometimes, these geometric formations degrade, which could indicate that Hydrogel Polymers are natural, rather than synthetic. Yes, the sodium may also contribute to the angular shapes.
Some of these ‘Smart City’ formations seemed a bit different than others I have seen before. Lots of isolated rectangles on the interior. You can see the Hydrogel Polymer bubbles as bright white thick-membraned vesicles, that eventually join the straight lines.
Also, these interesting scribbled layered rectangles of crystals formed from the yellow chemical ingredients.
Note, I did not see any “Microbots” or “Autonomously-Moving Particles”.
Needless to say, I wouldn’t recommend using this product. There are other treatments for Cancer-whatever ‘Cancer’ really is. And certainly, whatever this new ‘Turbo-Cancer’ is that has emerged since 2021 is Not what Cancer was before.
If anyone else has any other Pharmaceutical injections they would like me to look at, please send me a Direct Message here on Substack. Otherwise, I am working on the Unhackable-Animal.com website with all my investigations, and where you can directly contact me about investigating samples for a fee, buy the Book, as well as Donate.
In other news - I plan on buying a more affordable microscope to test out to find one for interested budding citizen microscopists. Stay Tuned!

Thank you so much am your biggest fan I'm going to share far and wide please follow me back can you please look at the velo and other nicotine pouches please https://substack.com/profile/277513869-william-cody-nalbach/note/c-239039964?r=4l832l&utm_source=notes-share-action&utm_medium=web
Thanks so much for this analysis!
My dermatologist wanted to inject this crap into a basal cell carcinoma. After seeing your work I pitched the stuff into the trash. Insurance wouldn't pay for it so $30. out of pocket but at this point who cares.
The dermatologist used a scalpel instead to scrape away the basal cell and as she said, healing would take longer but it was worth it.
I showed her the first photos you took and she was not interested in the evidence.
I am concerned about her driving a new Tesla with two young children as I think her first Tesla got her quite sick. Many doctors don't have the time to keep up with new information or they don't care to.